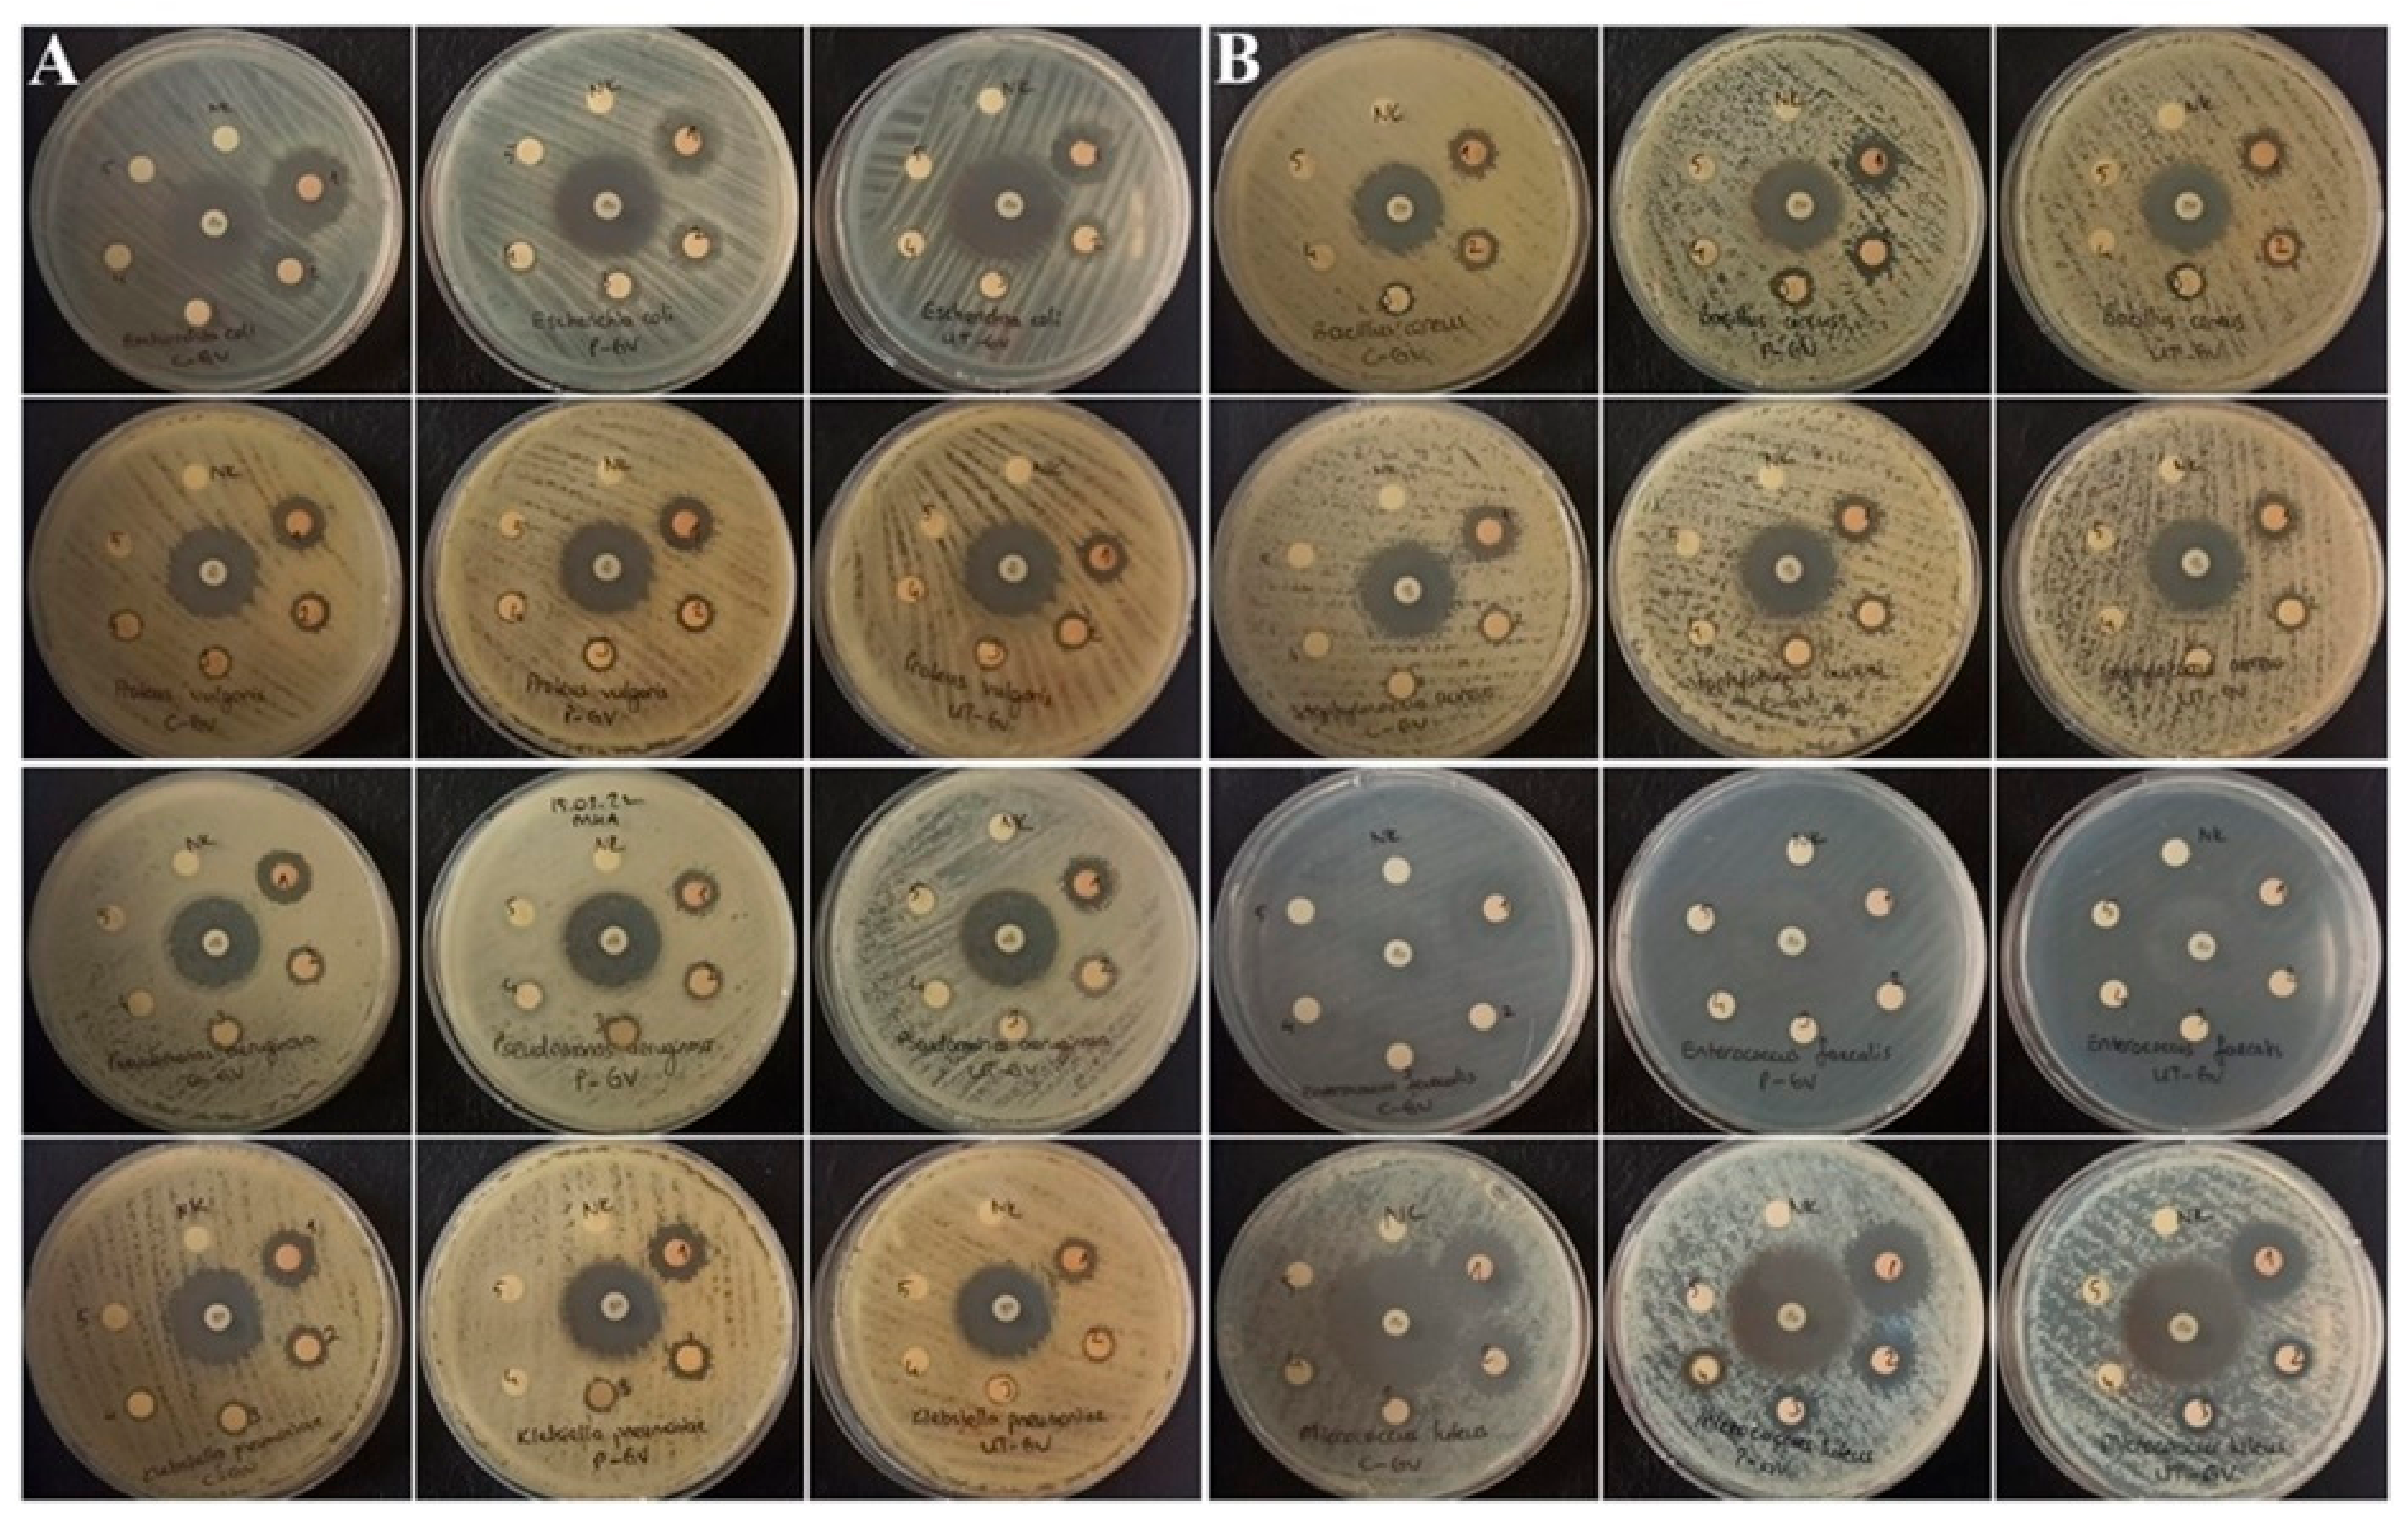
Biology 11 00926 g002

Effects of Non-Thermal Treatment on Gilaburu Vinegar (Viburnum opulus L.): Polyphenols, Amino Acid, Antimicrobial, and Anticancer Properties
Abstract
:Simple Summary
Abstract
1. Introduction
2. Materials and Methods
2.1. Preparation of Vinegar
2.2. Thermal Pasteurization and Ultrasound Treatments
2.3. Experimental Design
2.4. Determination of Bioactive Compounds
2.5. Analysis of Antimicrobial Activity
2.6. Analysis of Phenolic Compounds
2.7. Determination of Organic Acid Contents and Sugar Contents
2.8. Analysis of Minerals
2.9. Analysis of Amino Acids
2.10. Anticancer Activity
2.11. Analysis of Volatile Compounds
2.12. Statistical Analysis
3. Results and Discussion
3.1. Optimization of Bioactive Compounds
3.2. Analysis of Phenolic Compounds and Amino Acids
3.3. Minerals, Organic Acid, Sugars
3.4. Analysis of Antimicrobial Activity
3.5. Anticancer Activity
3.6. Volatile Compounds
4. Conclusions
Author Contributions
Funding
Institutional Review Board Statement
Informed Consent Statement
Data Availability Statement
Conflicts of Interest
References
- Gomes, R.J.; de Fatima Borges, M.; Castro-Gómez, R.J.H.; Spinosa, W.A. Acetic Acid Bacteria in the Food Industry: Systematics, Characteristics and Applications. Food Technol. Biotechnol. 2018, 56, 139. [Google Scholar] [CrossRef] [PubMed]
- Prisacaru, A.E.; Ghinea, C.; Apostol, L.C.; Ropciuc, S.; Ursachi, V.F. Physicochemical Characteristics of Vinegar from Banana Peels and Commercial Vinegars before and after In Vitro Digestion. Processes 2021, 9, 1193. [Google Scholar] [CrossRef]
- Ho, C.W.; Lazim, A.M.; Fazry, S.; Zaki, U.K.H.H.; Lim, S.J. Varieties, production, composition and health benefits of vinegars: A review. Food Chem. 2017, 221, 1621–1630. [Google Scholar] [CrossRef] [PubMed]
- Yıkmış, S.; Aksu, F.; Altunatmaz, S.S.; Çöl, B.G. Ultrasound Processing of Vinegar: Modelling the Impact on Bioactives and Other Quality Factors. Foods 2021, 10, 1703. [Google Scholar] [CrossRef] [PubMed]
- Yıkmış, S.; Bozgeyik, E.; Şimşek, M.A. Ultrasound processing of verjuice (unripe grape juice) vinegar: Effect on bioactive compounds, sensory properties, microbiological quality and anticarcinogenic activity. J. Food Sci. Technol. 2020, 57, 3445–3456. [Google Scholar] [CrossRef]
- Chiozzi, V.; Agriopoulou, S.; Varzakas, T. Advances, Applications, and Comparison of Thermal (Pasteurization, Sterilization, and Aseptic Packaging) against Non-Thermal (Ultrasounds, UV Radiation, Ozonation, High Hydrostatic Pressure) Technologies in Food Processing. Appl. Sci. 2022, 12, 2202. [Google Scholar] [CrossRef]
- Chavan, P.; Sharma, P.; Sharma, S.R.; Mittal, T.C.; Jaiswal, A.K. Application of High-Intensity Ultrasound to Improve Food Processing Efficiency: A Review. Foods 2022, 11, 122. [Google Scholar] [CrossRef]
- Brenes, X.; Guevara, M.; Wong, E.; Cortés, C.; Usaga, J.; Rojas-Garbanzo, C. Effect of high intensity ultrasound on main bioactive compounds, antioxidant capacity and color in orange juice. Food Sci. Technol. Int. 2021. [Google Scholar] [CrossRef]
- Yıkmış, S.; Bozgeyik, E.; Levent, O.; Aksu, H. Organic cherry laurel (Prunus laurocerasus) vinegar enriched with bioactive compounds with ultrasound technology using artificial neural network (ANN) and response surface methodology (RSM): Antidiabetic, antihypertensive, cytotoxic activities, volatile profile and optical microstructure. J. Food Process. Preserv. 2021, 45, e15883. [Google Scholar] [CrossRef]
- Wang, Z.; Li, T.; Liu, F.; Zhang, C.; Ma, H.; Wang, L.; Zhao, S. Effects of ultrasonic treatment on the maturation of Zhenjiang vinegar. Ultrason. Sonochem. 2017, 39, 272–280. [Google Scholar] [CrossRef]
- Manzoor, M.F.; Ahmed, Z.; Ahmad, N.; Aadil, R.M.; Rahaman, A.; Roobab, U.; Rehman, A.; Siddique, R.; Zeng, X.A.; Siddeeg, A. Novel processing techniques and spinach juice: Quality and safety improvements. J. Food Sci. 2020, 85, 1018–1026. [Google Scholar] [CrossRef]
- Kwaw, E.; Ma, Y.; Tchabo, W.; Sackey, A.S.; Apaliya, M.T.; Xiao, L.; Wu, M.; Sarpong, F. Ultrasonication effects on the phytochemical, volatile and sensorial characteristics of lactic acid fermented mulberry juice. Food Biosci. 2018, 24, 17–25. [Google Scholar] [CrossRef]
- Margean, A.; Lupu, M.I.; Alexa, E.; Padureanu, V.; Canja, C.M.; Cocan, I.; Negrea, M.; Calefariu, G.; Poiana, M.A. An Overview of Effects Induced by Pasteurization and High-Power Ultrasound Treatment on the Quality of Red Grape Juice. Molecules 2020, 25, 1669. [Google Scholar] [CrossRef] [Green Version]
- Kumar Gupta, A.; Pratim Sahu, P.; Mishra, P. Ultrasound aided debittering of bitter variety of citrus fruit juice: Effect on chemical, volatile profile and antioxidative potential. Ultrason. Sonochem. 2021, 81, 105839. [Google Scholar] [CrossRef]
- Zakłos-Szyda, M.; Kowalska-Baron, A.; Pietrzyk, N.; Drzazga, A.; Podsędek, A. Evaluation of Viburnum opulus L. Fruit Phenolics Cytoprotective Potential on Insulinoma MIN6 Cells Relevant for Diabetes Mellitus and Obesity. Antioxidants 2020, 9, 433. [Google Scholar] [CrossRef]
- Česoniene, L.; Daubaras, R.; Vencloviene, J.; Viškelis, P. Biochemical and agro-biological diversity of Viburnum opulus genotypes. Cent. Eur. J. Biol. 2010, 5, 864–871. [Google Scholar] [CrossRef]
- Martínez, M.L.; Maestri, D.M. Oil chemical variation in walnut (Juglans regia L.) genotypes grown in Argentina. Eur. J. Lipid Sci. Technol. 2008, 110, 1183–1189. [Google Scholar] [CrossRef]
- Konarska, A.; Domaciuk, M. Differences in the fruit structure and the location and content of bioactive substances in Viburnum opulus and Viburnum lantana fruits. Protoplasma 2018, 255, 25–41. [Google Scholar] [CrossRef] [Green Version]
- Sevindik, O.; Guclu, G.; Agirman, B.; Selli, S.; Kadiroglu, P.; Bordiga, M.; Capanoglu, E.; Kelebek, H. Impacts of selected lactic acid bacteria strains on the aroma and bioactive compositions of fermented gilaburu (Viburnum opulus) juices. Food Chem. 2022, 378, 132079. [Google Scholar] [CrossRef]
- Yıkmış, S. Optimization of Uruset Apple Vinegar Production Using Response Surface Methodology for the Enhanced Extraction of Bioactive Substances. Foods 2019, 8, 107. [Google Scholar] [CrossRef] [Green Version]
- Singleton, V.L.; Rossi, J.A. Colorimetry of Total Phenolics with Phosphomolybdic-Phosphotungstic Acid Reagents. Am. J. Enol. Vitic. 1965, 16, 144–158. [Google Scholar]
- Zhishen, J.; Mengcheng, T.; Jianming, W. The determination of flavonoid contents in mulberry and their scavenging effects on superoxide radicals. Food Chem. 1999, 64, 555–559. [Google Scholar] [CrossRef]
- Grajeda-Iglesias, C.; Salas, E.; Barouh, N.; Baréa, B.; Panya, A.; Figueroa-Espinoza, M.C. Antioxidant activity of protocatechuates evaluated by DPPH, ORAC, and CAT methods. Food Chem. 2016, 194, 749–757. [Google Scholar] [CrossRef]
- Apak, R.; Güçlü, K.; Özyürek, M.; Esin Karademir, S.; Erçağ, E. The cupric ion reducing antioxidant capacity and polyphenolic content of some herbal teas. Int. J. Food Sci. Nutr. 2006, 57, 292–304. [Google Scholar] [CrossRef]
- AOAC. Official Methods of Analysis of The Association Chemistis, 18th ed.; AOAC: Rockville, MD, USA, 2016. [Google Scholar]
- Wayne, P.; CLSI. Performance Standards for Antimicrobial Susceptibility Testing, M100, Clinical and Laboratory Standards Institute, 29th ed.; CLSI: New York, NY, USA, 2019. [Google Scholar]
- Wayne, P.; CLSI. Reference Method for Broth Dilution Antifungal Susceptibility Testing of Yeasts; Approved Standard; CLSI document M27-A3; Clinical Laboratory Standards Institute: New York, NY, USA, 2008. [Google Scholar]
- Portu, J.; López, R.; Santamaría, P.; Garde-Cerdán, T. Elicitation with methyl jasmonate supported by precursor feeding with phenylalanine: Effect on Garnacha grape phenolic content. Food Chem. 2017, 237, 416–422. [Google Scholar] [CrossRef]
- Coelho, E.M.; da Silva Padilha, C.V.; Miskinis, G.A.; de Sá, A.G.B.; Pereira, G.E.; de Azevêdo, L.C.; dos Santos Lima, M. Simultaneous analysis of sugars and organic acids in wine and grape juices by HPLC: Method validation and characterization of products from northeast Brazil. J. Food Compos. Anal. 2018, 66, 160–167. [Google Scholar] [CrossRef] [Green Version]
- Sezer, B.; Apaydin, H.; Bilge, G.; Boyaci, I.H. Detection of Pistacia vera adulteration by using laser induced breakdown spectroscopy. J. Sci. Food Agric. 2019, 99, 2236–2242. [Google Scholar] [CrossRef]
- Bilgin, Ö.; Çarli, U.; Erdoğan, S.; Emrah MAVİŞ, M.; Göksu Gürsu, G.; Yilmaz, M. Karadeniz’de (Sinop Yarımadası Civarı) Avlanan İzmarit Balığı, Spicara smaris (Linnaeus, 1758), Etinin LC-MS/MS Kullanarak Amino Asit İçeriğinin Tespiti ve Ağırlık-Boy İlişkisi. Türk Tarım ve Doğa Bilim. Derg. 2019, 6, 130–136. [Google Scholar] [CrossRef]
- Yıkmış, S. Sensory, physicochemical, microbiological and bioactive properties of red watermelon juice and yellow watermelon juice after ultrasound treatment. J. Food Meas. Charact. 2020, 14, 1417–1426. [Google Scholar] [CrossRef]
- Santhirasegaram, V.; Razali, Z.; Somasundram, C. Effects of thermal treatment and sonication on quality attributes of Chokanan mango (Mangifera indica L.) juice. Ultrason. Sonochem. 2013, 20, 1276–1282. [Google Scholar] [CrossRef]
- Bhat, R.; Kamaruddin, N.; Min-Tze, L.; Karim, A. Sonication improves kasturi lime (Citrus microcarpa) juice quality. Ultrason. Sonochem. 2011, 18, 1295–1300. [Google Scholar] [CrossRef]
- Zafra-Rojas, Q.Y.; Cruz-Cansino, N.; Ramírez-Moreno, E.; Delgado-Olivares, L.; Villanueva-Sánchez, J.; Alanís-García, E. Effects of ultrasound treatment in purple cactus pear (Opuntia ficus-indica) juice. Ultrason. Sonochem. 2013, 20, 1283–1288. [Google Scholar] [CrossRef] [PubMed]
- Wang, J.; Wang, J.; Ye, J.; Vanga, S.K.; Raghavan, V. Influence of high-intensity ultrasound on bioactive compounds of strawberry juice: Profiles of ascorbic acid, phenolics, antioxidant activity and microstructure. Food Control 2019, 96, 128–136. [Google Scholar] [CrossRef]
- Aadil, R.M.; Zeng, X.-A.; Han, Z.; Sun, D.-W. Effects of ultrasound treatments on quality of grapefruit juice. Food Chem. 2013, 141, 3201–3206. [Google Scholar] [CrossRef] [PubMed]
- Tiwari, B.K.; O’Donnell, C.P.; Patras, A.; Brunton, N.; Cullen, P.J. Stability of anthocyanins and ascorbic acid in sonicated strawberry juice during storage. Eur. Food Res. Technol. 2009, 228, 717–724. [Google Scholar] [CrossRef]
- Albuquerque, B.R.; Heleno, S.A.; Oliveira, M.B.P.P.; Barros, L.; Ferreira, I.C.F.R. Phenolic compounds: Current industrial applications, limitations and future challenges. Food Funct. 2021, 12, 14–29. [Google Scholar] [CrossRef] [PubMed]
- Chen, H.; Chen, T.; Giudici, P.; Chen, F. Vinegar Functions on Health: Constituents, Sources, and Formation Mechanisms. Compr. Rev. Food Sci. Food Saf. 2016, 15, 1124–1138. [Google Scholar] [CrossRef]
- Olawuyi, I.F.; Akbarovich, S.A.; Kim, C.K.; Lee, W.Y. Effect of combined ultrasound-enzyme treatment on recovery of phenolic compounds, antioxidant capacity, and quality of plum (Prunus salicina L.) juice. J. Food Process. Preserv. 2021, 45, e15074. [Google Scholar] [CrossRef]
- Wang, J.; Vanga, S.K.; Raghavan, V. High-intensity ultrasound processing of kiwifruit juice: Effects on the ascorbic acid, total phenolics, flavonoids and antioxidant capacity. LWT 2019, 107, 299–307. [Google Scholar] [CrossRef]
- Wang, J.; Liu, Q.; Xie, B.; Sun, Z. Effect of ultrasound combined with ultraviolet treatment on microbial inactivation and quality properties of mango juice. Ultrason. Sonochem. 2020, 64, 105000. [Google Scholar] [CrossRef]
- Abid, M.; Jabbar, S.; Wu, T.; Hashim, M.M.; Hu, B.; Lei, S.; Zhang, X.; Zeng, X. Effect of ultrasound on different quality parameters of apple juice. Ultrason. Sonochem. 2013, 20, 1182–1187. [Google Scholar] [CrossRef]
- Cruz-Cansino, N.d.S.; Ramírez-Moreno, E.; León-Rivera, J.E.; Delgado-Olivares, L.; Alanís-García, E.; Ariza-Ortega, J.A.; Manríquez-Torres, J.d.J.; Jaramillo-Bustos, D.P. Shelf life, physicochemical, microbiological and antioxidant properties of purple cactus pear (Opuntia ficus indica) juice after thermoultrasound treatment. Ultrason. Sonochem. 2015, 27, 277–286. [Google Scholar] [CrossRef]
- Cuéllar-Villarreal, M.d.R.; Ortega-Hernández, E.; Becerra-Moreno, A.; Welti-Chanes, J.; Cisneros-Zevallos, L.; Jacobo-Velázquez, D.A. Effects of ultrasound treatment and storage time on the extractability and biosynthesis of nutraceuticals in carrot (Daucus carota). Postharvest Biol. Technol. 2016, 119, 18–26. [Google Scholar] [CrossRef]
- Siddeeg, A.; Zeng, X.A.; Rahaman, A.; Manzoor, M.F.; Ahmed, Z.; Ammar, A.F. Quality characteristics of the processed dates vinegar under influence of ultrasound and pulsed electric field treatments. J. Food Sci. Technol. 2019, 56, 4380–4389. [Google Scholar] [CrossRef]
- Jambrak, A.R.; Mason, T.J.; Lelas, V.; Paniwnyk, L.; Herceg, Z. Effect of ultrasound treatment on particle size and molecular weight of whey proteins. J. Food Eng. 2014, 121, 15–23. [Google Scholar] [CrossRef]
- Ahmed, Z.; Manzoor, M.F.; Begum, N.; Khan, A.; Shah, I.; Farooq, U.; Siddique, R.; Zeng, X.A.; Rahaman, A.; Siddeeg, A. Thermo-Ultrasound-Based Sterilization Approach for the Quality Improvement of Wheat Plantlets Juice. Processes 2019, 7, 518. [Google Scholar] [CrossRef] [Green Version]
- Das, M.J.; Das, A.J.; Chakraborty, S.; Baishya, P.; Ramteke, A.; Deka, S.C. Effects of microwave combined with ultrasound treatment on the pasteurization and nutritional properties of bottle gourd (Lagenaria siceraria) juice. J. Food Process. Preserv. 2020, 44, e14904. [Google Scholar] [CrossRef]
- Aadil, R.M.; Zeng, X.A.; Wang, M.S.; Liu, Z.W.; Han, Z.; Zhang, Z.H.; Hong, J.; Jabbar, S. A potential of ultrasound on minerals, micro-organisms, phenolic compounds and colouring pigments of grapefruit juice. Int. J. Food Sci. Technol. 2015, 50, 1144–1150. [Google Scholar] [CrossRef]
- Ovodova, R.G.; Golovchenko, V.V.; Popov, S.V.; Shashkov, A.S.; Ovodov, S.Y. The isolation, preliminary structural studies, and physiological activity of water-soluble polysaccharides from the squeezed berries of the snowball treeViburnum opulus. Russ. J. Bioorg. Chem. 2000, 26, 54–59. [Google Scholar] [CrossRef]
- Česonienė, L.; Daubaras, R.; Kraujalytė, V.; Venskutonis, P.R.; Šarkinas, A. Antimicrobial activity of Viburnum opulus fruit juices and extracts. J. fur Verbrauch. und Leb. 2014, 9, 129–132. [Google Scholar] [CrossRef]
- Zongur, A.; Kavuncuoglu, H.; Kavuncuoglu, E.; Dursun Capar, T.; Yalcin, H.; Buzpinar, M.A. Machine learning approach for predicting the antifungal effect of gilaburu (Viburnum opulus) fruit extracts on Fusarium spp. isolated from diseased potato tubers. J. Microbiol. Methods 2022, 192, 106379. [Google Scholar] [CrossRef] [PubMed]
- Česonienė, L.; Daubaras, R.; Viškelis, P.; Šarkinas, A. Determination of the total phenolic and anthocyanin contents and antimicrobial activity of Viburnum opulus fruit juice. Plant Foods Hum. Nutr. 2012, 67, 256–261. [Google Scholar] [CrossRef] [PubMed]
- Wójcik-Bojek, U.; Rywaniak, J.; Bernat, P.; Podsędek, A.; Kajszczak, D.; Sadowska, B. An In Vitro Study of the Effect of Viburnum opulus Extracts on Key Processes in the Development of Staphylococcal Infections. Molecules 2021, 26, 1758. [Google Scholar] [CrossRef] [PubMed]
- Düz, M.; Korcan, S.E.; Akkuş, G.U. Determination of total phenolic, flavonoid content and antimicrobial properties in different solvent extracts of Viburnum opulus L. (gilaburu) in afyonkarahisar. Pakistan J. Anal. Environ. Chem. 2021, 22, 388–395. [Google Scholar] [CrossRef]
- Sagdic, O.; Aksoy, A.; Ozkan, G. Evaluation of the antibacterial and antioxidant potentials of cranberry (gilaburu, Viburnum opulus L.) fruit extract. Acta Aliment. 2006, 35, 487–492. [Google Scholar] [CrossRef]
- Eryilmaz, M.; Ozbilgin, S.; Ergene, B.; Sever Yilmaz, B.; Altun, M.L.; Saltan, G. Antimicrobial activity of Turkish Viburnum species. Bangladesh J. Bot. 2013, 42, 355–360. [Google Scholar] [CrossRef] [Green Version]
- Arslan, M.; Erbil, N.; Murathan, Z.T. Investigation of Antimicrobial, Antioxidant, and Antimutagenic Activities of Wild Guelder RoseFruit Extract Grown in Ardahan and Its Surrounding Area. Gümüşhane Üniversitesi Fen Bilim. Derg. 2018, 8, 18–25. [Google Scholar] [CrossRef] [Green Version]
- Milletli Sezgin, F.; Sevim, A.; Karakamiş, Ö.; Şahin, N.; Özdemir, B.; Sevim, E. Antifungal Activity of Viburnum opulus L. (Gilaburu) Fruit Extracts Against Candida Strains Isolated from Urine Samples. Erzincan Üniversitesi Fen Bilim. Enstitüsü Derg. 2017, 10, 232–242. [Google Scholar] [CrossRef]
- Zakłos-Szyda, M.; Pawlik, N.; Polka, D.; Nowak, A.; Koziołkiewicz, M.; Podsędek, A. Viburnum opulus Fruit Phenolic Compounds as Cytoprotective Agents Able to Decrease Free Fatty Acids and Glucose Uptake by Caco-2 Cells. Antioxidants 2019, 8, 262. [Google Scholar] [CrossRef] [Green Version]
- Koparal, A.T. In Vitro Evaluation of Gilaburu (Viburnum opulus L.) Juice on Different Cell Lines. Anadolu J. Educ. Sci. Int. 2019, 9, 549–571. [Google Scholar] [CrossRef] [Green Version]
- Zakłos-Szyda, M.; Pawlik, N. The influence of Viburnum opulus polyphenolic compounds on metabolic activity and migration of hela and mcf cells. Acta Innov. 2019, 33–42. [Google Scholar] [CrossRef] [Green Version]
- Ulger, H.; Ertekin, T.; Karaca, O.; Canoz, O.; Nisari, M.; Unur, E.; Elmalı, F. Influence of gilaburu (Viburnum opulus) juice on 1,2-dimethylhydrazine (DMH)-induced colon cancer. Toxicol. Ind. Health 2013, 29, 824–829. [Google Scholar] [CrossRef]
- Ceylan, D.; Aksoy, A.; Ertekin, T.; Yay, A.H.; Nisari, M.; Karatoprak, G.Ş.; Ülger, H. The effects of gilaburu (Viburnum opulus) juice on experimentally induced Ehrlich ascites tumor in mice. J. Cancer Res. Ther. 2018, 14, 314–320. [Google Scholar] [CrossRef]
- Tian, H.; Lu, C.; Zhan, P.; Wang, P.; Zhao, Y.; Tian, P. Effects of sterilization methods on pomegranate juice evaluated by descriptive sensory analysis and gas chromatography-mass spectrometry through partial least-squares regression. Flavour Fragr. J. 2020, 35, 674–685. [Google Scholar] [CrossRef]
- Ma, T.; Wang, J.; Wang, L.; Yang, Y.; Yang, W.; Wang, H.; Lan, T.; Zhang, Q.; Sun, X. Ultrasound-Combined Sterilization Technology: An Effective Sterilization Technique Ensuring the Microbial Safety of Grape Juice and Significantly Improving Its Quality. Foods 2020, 9, 1512. [Google Scholar] [CrossRef]

| Independent Variable | Factor Levels | ||||
|---|---|---|---|---|---|
| Lowest | Low | Center | High | Highest | |
| (−1.41) | (−1) | 0 | (+1) | (+1.41) | |
| Time (Factor 1, A) (min) | 2 | 5 | 8 | 11 | 14 |
| Amplitude (Factor 2, B) (%) | 40 | 55 | 70 | 85 | 100 |
| Run No. | Independent Variables | Dependent Variables | ||||||||||||
|---|---|---|---|---|---|---|---|---|---|---|---|---|---|---|
| Time (A) | Amplitude (B) | TPC (mg GAE/100 mL) | TFC (mg CE/100 mL) | TAC (mg Cy-3-gly/100 mL) | AA (mg/100 mL) | DPPH (% Inhibition) | CUPRAC (% Inhibition) | |||||||
| Experimental Data | RSM Predicted | Experimental Data | RSM Predicted | Experimental Data | RSM Predicted | Experimental Data | RSM Predicted | Experimental Data | RSM Predicted | Experimental Data | RSM Predicted | |||
| 1 | 11 (+1) | 55(−1) | 97.52 | 97.49 | 12.19 | 12.19 | 8.77 | 8.78 | 1.56 | 1.56 | 55.13 | 55.11 | 61.25 | 61.16 |
| 2 | 11 (+1) | 85 (+1) | 88.75 | 88.69 | 11.09 | 11.09 | 8.56 | 8.56 | 1.74 | 1.74 | 52.34 | 52.29 | 58.16 | 58.00 |
| 3 | 8(0) | 70 (0) | 92.75 | 92.77 | 11.60 | 11.60 | 8.58 | 8.57 | 1.61 | 1.61 | 54.04 | 54.29 | 60.04 | 60.12 |
| 4 | 2 (−1.41) | 70 (0) | 92.64 | 92.67 | 11.58 | 11.58 | 8.53 | 8.53 | 1.82 | 1.81 | 51.89 | 52.00 | 57.65 | 57.80 |
| 5 | 8(0) | 70 (0) | 92.75 | 92.77 | 11.60 | 11.60 | 8.57 | 8.57 | 1.61 | 1.61 | 54.30 | 54.29 | 60.04 | 60.12 |
| 6 | 8(0) | 70 (0) | 92.75 | 92.77 | 11.60 | 11.60 | 8.57 | 8.57 | 1.61 | 1.61 | 54.30 | 54.29 | 60.04 | 60.12 |
| 7 | 8(0) | 70 (0) | 92.75 | 92.77 | 11.60 | 11.60 | 8.57 | 8.57 | 1.61 | 1.61 | 54.30 | 54.29 | 60.04 | 60.12 |
| 8 | 14 (+1.41) | 70 (0) | 93.36 | 93.38 | 11.67 | 11.67 | 8.71 | 8.71 | 1.75 | 1.75 | 53.05 | 53.05 | 58.94 | 58.97 |
| 9 | 5 (−1) | 85 (+1) | 93.84 | 93.77 | 11.73 | 11.73 | 8.65 | 8.65 | 1.64 | 1.64 | 53.71 | 53.56 | 59.68 | 59.44 |
| 10 | 8 (0) | 100 (+1.41) | 89.68 | 89.71 | 11.21 | 11.22 | 8.68 | 8.69 | 1.72 | 1.71 | 51.55 | 51.60 | 57.28 | 57.38 |
| 11 | 5 (−1) | 55 (−1) | 91.76 | 91.70 | 11.47 | 11.47 | 8.51 | 8.51 | 1.72 | 1.72 | 52.97 | 52.78 | 58.85 | 58.54 |
| 12 | 8 (0) | 70 (0) | 92.75 | 92.77 | 11.60 | 11.60 | 8.57 | 8.57 | 1.61 | 1.61 | 54.30 | 54.29 | 60.04 | 60.12 |
| 13 | 6 (0) | 40 (−1.41) | 92.72 | 92.74 | 11.59 | 11.59 | 8.64 | 8.63 | 1.73 | 1.73 | 52.02 | 52.08 | 57.80 | 57.90 |
| C-GV | 92.26 | 11.10 | 8.5 | 2.35 | 50.92 | 56.54 | ||||||||
| P-GV | 90.74 | 9.68 | 7.9 | 1.56 | 48.60 | 52.85 | ||||||||
| Source | DF | F-Value | p-Value | F-Value | p-Value | F-Value | p-Value | F-Value | p-Value | p-Value | p-Value | F-Value | p-Value |
|---|---|---|---|---|---|---|---|---|---|---|---|---|---|
| TPC (mg GAE/100 mL) | TFC (mg CE/100 mL) | TAC (mg Cy-3-gly/100 mL) | AA (mg/100 mL) | DPPH (% Inhibition) | CUPRAC (% Inhibition) | ||||||||
| Model | 5 | 3896.75 | 0.00000 | 10,322.31 | 0.00000 | 320.69 | 0.00000 | 2152.32 | 0.00000 | 152.89 | 0.00000 | 90.57 | 0.000000 |
| Linear | 2 | 5714.21 | 0.00000 | 15115.1 | 0.00000 | 314.37 | 0.00000 | 710.19 | 0.00000 | 80.88 | 0.00000 | 54.06 | 0.000000 |
| A | 1 | 145.71 | 0.00001 | 370.8 | 0.00000 | 563.6 | 0.00000 | 492.07 | 0.00000 | 40.64 | 0.00000 | 27.78 | 0.001000 |
| B | 1 | 11,424.47 | 0.00000 | 30,222.06 | 0.00000 | 105.62 | 0.00000 | 1051.49 | 0.00000 | 133.6 | 0.00000 | 88.75 | 0.000000 |
| Square | 2 | 34.34 | 0.00024 | 62.01 | 0.00000 | 358.48 | 0.00000 | 3234.75 | 0.00000 | 161.59 | 0.00000 | 83.31 | 0.000000 |
| A2 | 1 | 35.69 | 0.00056 | 59.62 | 0.00000 | 72.14 | 0.00000 | 6420.62 | 0.00000 | 219.86 | 0.00000 | 114.43 | 0.000000 |
| B2 | 1 | 47.74 | 0.00023 | 90.56 | 0.00000 | 709.4 | 0.00000 | 590.74 | 0.00000 | 173.04 | 0.00000 | 88.05 | 0.000000 |
| 2-Way Interaction | 1 | 12,459.79 | 0.00000 | 32,911.97 | 0.00000 | 741.54 | 0.00000 | 2704.48 | 0.00000 | 173.38 | 0.00000 | 119.42 | 0.000000 |
| A*B | 1 | 12,459.79 | 0.00000 | 32,911.97 | 0.00000 | 741.54 | 0.00000 | 2704.48 | 0.00000 | 173.38 | 0.00000 | 119.42 | 0.000000 |
| Error | 7 | ||||||||||||
| Lack-of-Fit | 3 | * | * | * | * | 2.31 | 0.21800 | * | * | 2.19 | 0.23100 | * | * |
| Pure Error | 4 | ||||||||||||
| Total | 12 | ||||||||||||
| R2 | 99.96% | 99.99% | 99.57% | 99.93% | 99.09% | 98.48% | |||||||
| Adj R2 | 99.94% | 99.98% | 99.25% | 99.89% | 98.44% | 97.39% | |||||||
| Pred. R2 | 99.75% | 99.90% | 96.49% | 99.44% | 95.66% | 89.96% | |||||||
| Variable | Setting | |||
|---|---|---|---|---|
| Time (A) (min) | 14 | |||
| Amplitude (B) (%) | 61.2 | |||
| Response (UT-GV) | Fit | SE Fit | 95% CI | 95% PI |
| TPC (mg GAE/100 mL) | 97.58 | 0.056 | (97.4447; 97.7095) | (97.3982; 97.7561) |
| TFC (mg CE/100 mL) | 12.20 | 0.004 | (12.1853; 12.2057) | (12.1817; 12.2093) |
| TAC (mg Cy-3-gly/100 mL) | 8.83 | 0.007 | (8.81751; 8.85173) | (8.81150; 8.85774) |
| AA (mg/100 mL) | 1.66 | 0.003 | (1.65730; 1.67088) | (1.65492; 1.67327) |
| DPPH (% Inhibition) | 54.26 | 0.157 | (53.884; 54.628) | (53.753; 54.758) |
| CUPRAC (% Inhibition) | 60.36 | 0.213 | (59.853; 60.861) | (59.675; 61.038) |
| Studied Compound | Samples | |||
|---|---|---|---|---|
| C-GV | P-GV | UT-GV | ||
| Phenolic compounds (μg/mL) | Ascorbic acid | 4.61 ± 0.03 b | 3.66 ± 0.09 a | 4.40 ± 0.00 b |
| Gallic acid | 102.35 ± 0.65 b | 93.38 ± 0.09 a | 103.57 ± 0.53 b | |
| Protocatechuic acid | 2.08 ± 0.06 b | 1.77 ± 0.01 a | 3.25 ± 0.04 c | |
| Hydroxybenzoic acid | 0.90 ± 0.42 a | 0.85 ± 0.54 a | 1.41 ± 0.63 a | |
| Vanillic acid | 1.78 ± 1.62 a | 1.55 ± 1.59 a | 2.24 ± 2.31 a | |
| Gentisic acid | 0.47 ± 0.66 a | 0.35 ± 0.49 a | 0.05 ± 0.07 a | |
| p-coumaric acid | 0.10 ± 0.02 a | 0.05 ± 0.01 a | 0.12 ± 0.01 b | |
| Rutin | 0.13 ± 0.18 a | 0.23 ± 0.01 a | 0.48 ± 0.11 a | |
| Ferulic acid | 0.22 ± 0.01 a | 0.13 ± 0.11 a | 0.29 ± 0.25 a | |
| o-coumaric acid | 0.77 ± 0.01 a | 0.56 ± 0.13 a | 1.27 ± 0.01 b | |
| Neohesperidin | 0.98 ± 0.03 b | 0.81 ± 0.06 a | 1.06 ± 0.01 b | |
| Coumarin | 0.02 ± 0.01 a | 0.00 ± 0.00 a | 0.00 ± 0.00 a | |
| Quercetin | 0.14 ± 0.12 a | 0.07 ± 0.04 a | 0.20 ± 0.21 a | |
| trans-cinnamic acid | 0.21 ± 0.01 a | 0.16 ± 0.01 b | 0.23 ± 0.01 a | |
| Flavon | 0.02 ± 0.02 a | 0.00 ± 0.00 | 0.00 ± 0.00 | |
| Amino acid content (mg/100 mL) | Alanine | 1.49 ± 0.01 b | 1.42 ± 0.00 a | 1.44 ± 0.00 a |
| Arginine | 2.38 ± 0.00 b | 2.30 ± 0.00 a | 2.42 ± 0.00 c | |
| Aspartic Acid | 1.49 ± 0.00 c | 1.41 ± 0.00 b | 1.37 ± 0.00 a | |
| Cystine | n.d | n.d | n.d | |
| Glutamic Acid | 1.05 ± 0.03 a | 1.09 ± 0.01 a | 1.01 ± 0.05 a | |
| Glycine | 0.62 ± 0.06 a | 0.66 ± 0.04 a | 0.67 ± 0.05 a | |
| Histidine | 0.99 ± 0.01 a | 1.03 ± 0.03 a | 1.15 ± 0.00 b | |
| Isoleucine | 0.49 ± 0.00 a | 0.50 ± 0.01 ab | 0.53 ± 0.01 b | |
| Leucine | 2.03 ± 0.07 a | 1.92 ± 0.00 a | 2.09 ± 0.04 a | |
| Lysine | 1.87 ± 0.00 a | 1.88 ± 0.00 b | 1.96 ± 0.00 c | |
| Methionine | 0.28 ± 0.00 a | 0.29 ± 0.00 a | 0.28 ± 0.01 a | |
| Ornitine | 0.64 ± 0.00 c | 0.60 ± 0.00 b | 0.57 ± 0.00 a | |
| Phenylalanine | 1.20 ± 0.00 a | 1.19 ± 0.04 a | 1.27 ± 0.03 a | |
| Proline | 17.33 ± 0.06 a | 17.95 ± 0.00 b | 18.52 ± 0.03 c | |
| Serine | 0.53 ± 0.00 b | 0.46 ± 0.01 a | 0.54 ± 0.01 b | |
| Threonine | 0.71 ± 0.03 a | 0.78 ± 0.00 a | 0.75 ± 0.00 a | |
| Tyrosine | 0.78 ± 0.02 a | 0.81 ± 0.06 a | 0.89 ± 0.01 a | |
| Valine | 0.98 ± 0.02 ab | 0.94 ± 0.01 a | 1.03 ± 0.00 b | |
| Taurine | n.d | n.d | n.d | |
| Studied Compound | Samples | |||
|---|---|---|---|---|
| C-GV | P-GV | UT-GV | ||
| Organic acid content (g/L) | Tartaric acid | 0.94 ± 0.11 a | 0.92 ± 0.14 a | 1.30 ± 0.33 a |
| Pyruvic acid | 0.09 ± 0.01 a | 0.05 ± 0.07 a | 0.14 ± 0.00 b | |
| Acetic acid | 62.68 ± 0.66 a | 68.50 ± 0.71 a | 97.10 ± 0.50 c | |
| Sugar content (g/L) | Maltose | 0.84 ± 0.05 a | 0.72 ± 0.16 a | 0.60 ± 0.02 a |
| Glicose | 1.24 ± 0.05 b | 0.85 ± 0.01 a | 0.86 ± 0.04 a | |
| Turanose | 1.92 ± 0.24 a | 1.34 ± 0.06 a | 1.35 ± 0.09 a | |
| Sucrose | 3.37 ± 0.12 b | 2.44 ± 0.11 a | 2.63 ± 0.06 a | |
| Ksilose | 1.28 ± 0.02 b | 0.83 ± 0.14 a | 0.62 ± 0.01 a | |
| Arabinose | 3.52 ± 0.88 b | 0.00 ± 0.00 a | 1.67 ± 0.15 ab | |
| Minerals (mg/L) | Ag | n.d | n.d | n.d |
| Al | n.d | n.d | n.d | |
| Ca | 0.42 ± 0.01 a | 0.38 ± 0.00 b | 0.36 ± 0.00 c | |
| Cd | n.d | n.d | n.d | |
| Co | n.d | n.d | n.d | |
| Cr | n.d | n.d | n.d | |
| Cu | n.d | n.d | n.d | |
| Fe | 0.05 ± 0.01 b | 0.04 ± 0.00 b | 0.39 ± 0.00 a | |
| K | 2.25 ± 0.01 a | 2.08 ± 0.01 b | 2.06 ± 0.01 b | |
| Mg | 0.44 ± 0.01 a | 0.33 ± 0.01 c | 0.35 ± 0.00 b | |
| Mn | 0.77 ± 0.01 a | 0.69 ± 0.00 b | 0.68 ± 0.00 b | |
| Na | n.d | n.d | n.d | |
| Ni | n.d | n.d | n.d | |
| Pb | n.d | n.d | n.d | |
| Zn | 0.03 ± 0.01 a | 0.02 ± 0.00 a | 0.03 ± 0.00 a | |
| Bacteria Strains | Zone Diameter (Mean ± SD, mm) | ||||||||||||
|---|---|---|---|---|---|---|---|---|---|---|---|---|---|
| C-GV | P-GV | UT-GV | CN | ||||||||||
| 100% | 50% | 25% | 12.5% | 100% | 50% | 25% | 12.5% | 100% | 50% | 25% | 12.5% | 10 µg/mL | |
| Escherichia coli | 22.04 ± 0.22 | 14.02 ± 0.08 | 10.25 ± 0.34 | 7.33 ± 0.42 | 21.03 ± 0.20 | 13.06 ± 0.20 | 10.26 ± 0.36 | 7.03 ± 0.06 | 15.05 ± 0.13 | 11.07 ± 0.09 | 7.11 ± 0.11 | ND | 21.38 ± 0.45 |
| Proteus vulgaris | 13.08 ± 0.30 | 10.27 ± 0.36 | 8.03 ± 0.23 | 7.03 ± 0.08 | 14.03 ± 0.10 | 10.20 ± 0.20 | 9.04 ± 0.12 | 8.03 ± 0.06 | 12.02 ± 0.28 | 10.01 ± 0.20 | 9.02 ± 0.09 | 7.08 ± 0.11 | 22.20 ± 0.20 |
| Pseudomonas aeruginosa | 18.05 ± 0.14 | 11.35 ± 0.44 | 10.08 ± 0.10 | n.d | 10.22 ± 0.57 | 9.07 ± 0.27 | 8.07 ± 0.21 | 7.05 ± 0.13 | 15.03 ± 0.08 | 9.10 ± 0.10 | 8.02 ± 0.09 | 7.04 ± 0.12 | 23.05 ± 0.13 |
| Klebsiella pneumoniae | 15.04 ± 0.12 | 10.03 ± 0.15 | 8.00 ± 0.25 | 7.23 ± 0.32 | 15.15 ± 0.22 | 10.33 ± 0.47 | 7.03 ± 0.10 | n.d | 10.08 ± 0.10 | 8.06 ± 0.13 | 7.02 ± 0.08 | n.d | 22.15 ± 0.18 |
| Bacillus cereus | 12.32 ± 0.47 | 10.31 ± 0.39 | 7.03 ± 0.10 | n.d | 14.17 ± 0.22 | 12.33 ± 0.35 | 10.05 ± 0.18 | n.d | 12.28 ± 0.33 | 9.00 ± 0.14 | 7.04 ± 0.10 | n.d | 23.03 ± 0.15 |
| Staphylococcus aureus | 14.30 ± 0.45 | 9.08 ± 0.26 | 8.02 ± 0.09 | n.d | 12.17 ± 0.21 | 9.24 ± 0.53 | 8.15 ± 0.13 | n.d | 13.11 ± 0.15 | 9.28 ± 0.35 | 8.03 ± 0.10 | n.d | 24.04 ± 0.20 |
| Enterococcus faecalis | 12.05 ± 0.21 | n.d | n.d | n.d | 12.05 ± 0.11 | n.d | n.d | n.d | 11.08 ± 0.17 | n.d | n.d | n.d | 18.17 ± 0.25 |
| Micrococcus luteus | 20.62 ± 0.58 | 16.04 ± 0.21 | 9.30 ± 0.35 | 8.25 ± 0.34 | 21.21 ± 0.48 | 15.10 ± 0.21 | 10.05 ± 0.20 | 8.03 ± 0.10 | 20.20 ± 0.48 | 11.36 ± 0.34 | 8.02 ± 0.08 | n.d | 33.09 ± 0.30 |
| Fungi Strains | C-GV (%) | P-GV (%) | UT-GV (%) | FLC (µg/mL) | VOR (µg/mL) | |||||
|---|---|---|---|---|---|---|---|---|---|---|
| MIC | MFC | MIC | MFC | MIC | MFC | MIC | MFC | MIC | MFC | |
| Candida albicans | 6.25 | 6.25 | 6.25 | 6.25 | 6.25 | 6.25 | 4 | 8 | n.d | n.d |
| Candida parapsilosis | 6.25 | 12.5 | 6.25 | 12.5 | 6.25 | 12.5 | n.d | n.d | 0.0625 | 0.125 |
| Compound | RI | C-GV (µg/L) | P-GV (µg/L) | UT-GV(µg/L) |
|---|---|---|---|---|
| Ethyl acetate | 884 | 1.66 ± 0.13 a | 0.64 ± 0.12 b | 1.35 ± 0.13 a |
| 2-Butanone | 904 | 0.72 ± 0.19 a | 0.51 ± 0.04 a | 0.62 ± 0.04 a |
| 2-Propanol | 924 | 22.90 ± 1.61 a | 25.35 ± 3.01 a | 22.64 ± 0.96 a |
| Ethanol | 932 | 102.04 ± 4.79 a | 111.51 ± 2.77 a | 107.54 ± 2.52 a |
| Hexanal | 1079 | 1.03 ± 0.20 a | 0.44 ±0.06 b | 0.74 ± 0.09 ab |
| 2-Methyl-1-propanol | 1092 | 24.01 ± 1.50 a | 21.19 ± 1.87 a | 22.20 ± 1.75 a |
| 2-Hexanone | 1097 | 1.71 ± 0.23 a | 0.91 ± 0.08 b | 1.36 ± 0.13 ab |
| 3-Pentanol | 1109 | 34.79 ± 1.88 a | 42.12 ± 1.93 a | 39.34 ± 2.52 a |
| Butanol | 1157 | 45.81 ± 2.93 a | 55.16 ± 3.26 a | 46.47 ± 2.89 a |
| 2-Heptanone | 1182 | 3.49 ± 0.35 a | 2.04 ± 0.12 b | 2.79 ± 0.18 ab |
| 3-Hexanol | 1189 | 46.73 ± 1.54 b | 59.01 ± 1.63 a | 51.17 ± 2.76 ab |
| 3-methyl-1-butanol | 1205 | 114.08 ± 6.12 a | 130.51 ± 4.16 a | 116.82 ± 4.75 a |
| 1-Pentanol | 1266 | 9.42 ± 0.93 a | 7.17 ± 0.96 ab | 5.79 ± 0.47 b |
| ρ-Cymene | 1275 | 0.21 ± 0.05 a | n.d | 0.13 ± 0.04 a |
| Hexyl acetate | 1281 | 2.37 ± 0.16 a | 0.89 ± 0.13 b | 1.87 ± 0.11 a |
| Octanal | 1292 | 0.54 ± 0.10 a | n.d | 0.41 ± 0.13 a |
| 2-Octanone | 1299 | 0.82 ± 0.11 a | 0.41 ± 0.07 b | 0.56 ± 0.09 ab |
| 6-Methyl-5-hepten-2-one | 1342 | 1.61 ± 0.17 a | 0.72 ± 0.19 b | 1.09 ± 0.18 ab |
| 1-Hexanol | 1353 | 66.45 ± 3.82 a | 61.44 ± 2.38 a | 70.95 ± 3.97 a |
| Nonanal | 1392 | 3.54 ± 0.30 a | 1.62 ± 0.19 b | 2.79 ± 0.18 a |
| 2-Nonanone | 1397 | 1.46 ± 0.18 a | 1.04 ± 0.12 a | 1.48 ± 0.13 a |
| Acetic acid | 1458 | 321.51 ± 9.84 a | 237.03 ± 10.58 b | 288.09 ± 12.28 a |
| Butanoic acid | 1630 | 101.75 ± 4.1 a | 63.62 ± 5.44 b | 84.25 ± 6.10 ab |
| 1-Nonanol | 1661 | 3.93 ± 0.27 a | 3.91 ± 0.51 a | 3.42 ± 0.66 a |
| Isovaleric acid | 1682 | 421.05 ± 10.46 a | 276.71 ± 26.64 b | 348.67 ± 19.49 ab |
| Pentanoic acid | 1735 | 7.51 ±1.30 a | 3.10 ± 0.77 a | 4.73 ± 1.05 a |
| Hexanoic acid | 1849 | 21.11 ± 3.74 a | 13.70 ± 1.22 a | 16.73 ± 1.82 a |
| Phenylethyl alcohol | 1918 | 69.37 ± 6.48 a | 78.86 ± 5.53 a | 71.95 ± 1.94 a |
| Octanoic acid | 2061 | 30.92 ± 3.34 a | 18.57 ± 1.54 b | 24.97 ± 3.4 ab |
| Nonanoic acid | 2159 | 66.95 ± 4.79 a | 43.49 ± 3.73 b | 61.42 ± 5.37 ab |
| Decanoic acid | 2251 | 37.49 ± 2.86 a | 19.18 ± 2.36 b | 30.79 ± 1.88 a |
| Total (µg/L) | ||||
| Esters | 4.0 | 1.5 | 3.2 | |
| Alcohols | 466.2 | 513.4 | 482.9 | |
| Aldehydes | 5.1 | 2.1 | 3.9 | |
| Ketones | 9.8 | 5.6 | 7.9 | |
| Acids | 354.6 | 257.7 | 313.4 | |
| Terpenes | 0.2 | 0.0 | 0.1 |
Publisher’s Note: MDPI stays neutral with regard to jurisdictional claims in published maps and institutional affiliations. |
© 2022 by the authors. Licensee MDPI, Basel, Switzerland. This article is an open access article distributed under the terms and conditions of the Creative Commons Attribution (CC BY) license (https://creativecommons.org/licenses/by/4.0/).
Share and Cite
Erdal, B.; Yıkmış, S.; Demirok, N.T.; Bozgeyik, E.; Levent, O. Effects of Non-Thermal Treatment on Gilaburu Vinegar (Viburnum opulus L.): Polyphenols, Amino Acid, Antimicrobial, and Anticancer Properties. Biology 2022, 11, 926. https://doi.org/10.3390/biology11060926
Erdal B, Yıkmış S, Demirok NT, Bozgeyik E, Levent O. Effects of Non-Thermal Treatment on Gilaburu Vinegar (Viburnum opulus L.): Polyphenols, Amino Acid, Antimicrobial, and Anticancer Properties. Biology. 2022; 11(6):926. https://doi.org/10.3390/biology11060926
Chicago/Turabian StyleErdal, Berna, Seydi Yıkmış, Nazan Tokatlı Demirok, Esra Bozgeyik, and Okan Levent. 2022. "Effects of Non-Thermal Treatment on Gilaburu Vinegar (Viburnum opulus L.): Polyphenols, Amino Acid, Antimicrobial, and Anticancer Properties" Biology 11, no. 6: 926. https://doi.org/10.3390/biology11060926
APA StyleErdal, B., Yıkmış, S., Demirok, N. T., Bozgeyik, E., & Levent, O. (2022). Effects of Non-Thermal Treatment on Gilaburu Vinegar (Viburnum opulus L.): Polyphenols, Amino Acid, Antimicrobial, and Anticancer Properties. Biology, 11(6), 926. https://doi.org/10.3390/biology11060926

